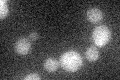
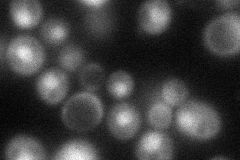
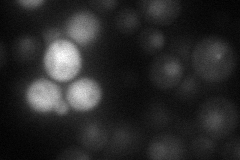
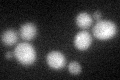

View description
Conserved protein that has an E3-like ubiquitin ligase activity necessary for polyubiquitination and degradation of the gluconeogenic enzyme fructose-1,6-bisphosphatase; also required for sporulation; has a degenerate RING finger domain
Localization:
Intensity:
Fold change:
Significance:
-
C’ GFP library in SD
below threshold17.83 -
N' NOP1pr-GFP in SD
nucleus54.0077 -
N' TEF2pr-mCherry in SD
nucleus24.0349 -
N' NATIVEpr-GFP in SD

below threshold15.5309 -
N' TEF2pr-VC and Cyto-VN in SD

below threshold26.9089 -
C’ GFP library in SD+DTT
cytosol21.161.18No -
C’ GFP library in SD+H2O2

cytosol19.461.09No -
C’ GFP library in Starvation Media

cytosol20.271.13No -
C’ GFP library on the background of Pup2-DaMP

below threshold -
C’ GFP library on the background of CCT mutant

below threshold19.36351.08539No
